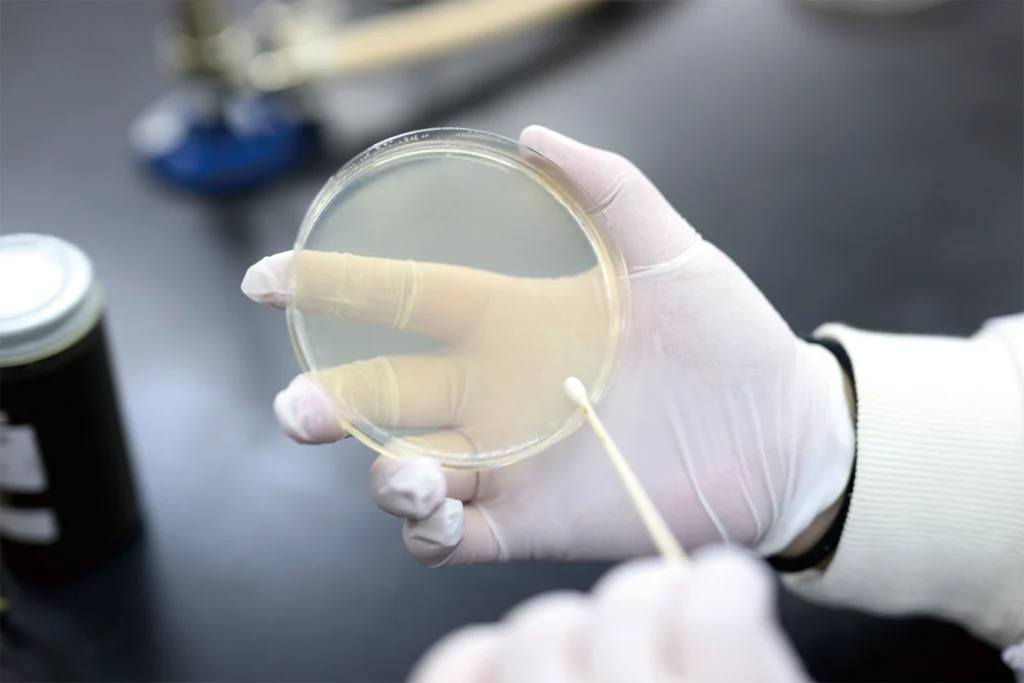

医療がますます高度化、複雑化する中、
臨床検査技師は「チーム医療」の一翼を担う
欠かすことのできない存在です。
チーム医療とは、一人の患者さんに対して、医師や看護師、臨床検査技師、薬剤師、管理栄養士などさまざまなスキルを持つ医療スタッフが連携し、協働しながら治療やケアに当たることです。
臨床検査技師は、医師の指示のもと、患者さんの病気の診断や治療のために必要な検査を行います。
血液検査やエコー検査、心電図検査なども臨床検査技師の仕事で、何よりも責任感とスキルが求められます。
患者さんの回復を喜びに、主に医療施設で医師や看護師などと共にチーム医療の一員として医療に貢献している、それが臨床検査技師です。

医師の診断支援に重要な「臨床検査データ」を分析・管理する国家資格を持ったエキスパート「臨床検査技師」。
医師の指示に基づいてさまざまな検査を行う臨床検査技師は、検査の専門知識や技術を持つ存在として医療現場で重要視されています。
臨床検査技師がいなければ病気の診断や治療は成り立たない、といっても過言ではありません。
近年、医療の進歩とともに検査技術などの進化もめざましく、臨床検査技師が手掛ける業務は拡大しています。
また、「予防医学」への意識が高まりつつある中、臨床検査技師の役割はますます重要になってくると予想されます。



臨床検査技師の業務と
検査の種類
臨床検査は、「検体検査」と「生理検査」の
二つに大きく分けられます。
「検体検査」は、血液や尿など患者さんの体から取り出した検体について、そこに含まれる成分や細胞の形や数などを調べる検査です。一方、「生理検査(生理機能検査)」は、心電図や超音波、脳波など患者さんの体を直接調べる検査です。
それらの検査で得られた結果は、医師の診断や治療に欠かすことのできない情報です。最近はチーム医療が主流ですが、臨床検査技師もその重要な一員として、他の医療スタッフと共に積極的に診療に関わることが多くなっています。

生理検査
- 心電図検査
- 胸部、両手足に電極を貼り付け、心臓の電気的活動を記録します。
- 超音波(エコー)検査
- 体の表面に超音波プローブをあて、体内の臓器から反射してきた超音波を画像として映し出し体内の病変を調べます。
- 脳波検査
- 頭部に電極を多数装着し、脳の活動を記録します。
- 肺機能検査
- マウスピースをくわえて息を吸ったり吐いたりしてもらい、肺から出入りする空気量などから肺の柔らかさ、空気の通り道の状態を検査します。
- 聴力検査
- 耳にヘッドホンを装着し、音を聴き取る能力を検査します。
- 神経伝導検査
- 手足の神経に電気刺激を与えて、神経や筋肉の働きを検査します。



検体検査
- 血液検査
- 血液中にある赤血球、白血球、血小板などの細胞や血液凝固因子を検査します。
- 微生物検査
- 感染症の原因微生物を培養などによって発見、検出し、有効な治療薬を調べます。
- 病理検査
- 患者さんの身体から組織や体液を採取してそこにある細胞を顕微鏡で観察することにより、確定的な診断へつなげる検査です。
- 免疫検査
- ヒトの免疫をつかさどる抗体やリンパ球を検査して、感染症の補助診断やアレルギーなどを検査します。
- 生化学検査
- 血液中の電解質、糖、脂質、タンパク質などのさまざまな成分を化学的に測定します。
- 一般・寄生虫検査
- 尿や糞便に代表される、患者の痛みを伴わずに得られる検査材料を用いて、さまざまな病気を発見できる、患者さんにやさしい検査です。
- 遺伝子検査
- 遺伝病の診断やガン細胞の遺伝子診断はもとより、体内にある病原微生物のDNAを検出することによる、より高感度な検査です。

病院をはじめ、
活躍の場は広がっています。
全ての検査が病院内で行われる時代は終わりました。今は病院から検査を請け負う臨床検査センターなどの企業によっても臨床検査が行われています。また人材派遣業の進出、治験ビジネス、医療機器インストラクターなど検査技師の領域は多様化しています。
病院
総合病院、一般病院、
大学病院、その他の病院
検査所
医師会検査センター、
検査企業など
健診センター
労働衛生研究所、
医師会健診センターなど
企業
治験企業、
試薬プロパーなど
その他
保健所、学校教育施設、
公衆衛生機関など
臨床検査技師の求人数は安定傾向
「臨床検査技師」という資格制度は1970年から施行された、比較的新しい資格です。制度が開始されてから臨床検査技師の数は増加していき、現在病院に勤める臨床検査技師の数は約6万人くらいいると推定されます。
本校の求人数も平成の始めくらいまでは順調に推移していましたが、毎年2000名の検査技師が生まれるため職場は飽和状態となり、加えて臨床検査のオートメーション化、病院の合理化、雇用形態の変化などで求人は落ち込んでいきました。
しかし現在では求人数は上向きに推移しています。それは現在病院で働いている臨床検査技師の定年退職者が出始めたためで、検査技師の求人数は制度が始まったころの水準に迫ろうとしています。今やっと各年代の検査技師ががほぼ均等に存在する状況になったのです。これから退職を迎える世代の数がある程度一定となり、新規雇用も安定してくると考えられます。ようやく検査技師という職業が成熟期に入ったと言えるでしょう。
